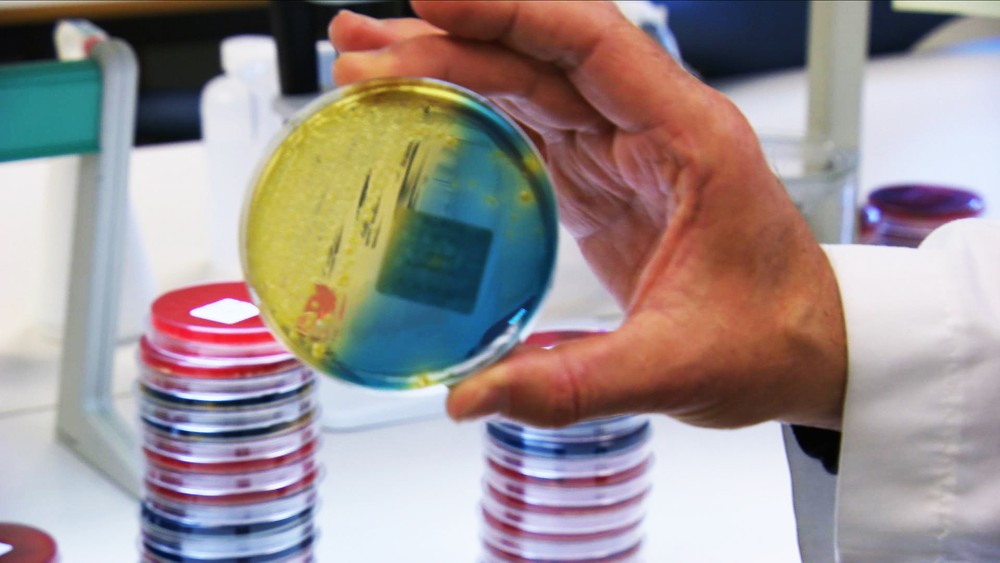
Extraña enfermedad mata a 26 perros en Noruega - pruebas-positivas-a-virus-hallados-en-perros-que-murieron

Autoridades sanitarias pidieron a los dueños de mascotas que eviten que sus perros entren en contacto con otros, a fin de prevenir contagios y muertes
Las autoridades sanitarias investigan la muerte de 26 perros en los últimos días en todo Noruega por una enfermedad aún sin identificar pero en la que aparecen síntomas similares, como inflamación intestinal y diarrea.
El Instituto Veterinario Noruego ha recibido decenas de casos de perros enfermos con síntomas parecidos en 14 de las 18 regiones del país -la mayoría se concentran en el área de Oslo-, pero consideran que es demasiado pronto para saber si hay una conexión entre todos.
En siete de los diez perros a los que se le ha practicado la autopsia desde el fin de semana se encontraron las bacterias “Providencia alcalifaciens” y “Clostridium perfringens“, aunque en los tres últimos casos analizados solo apreció la primera, informó este lunes el citado organismo sanitario.
Las autoridades han pedido a veterinarios de todo el país que registren todos los casos de perros con diarrea con sangre, vómitos y reducción de las facultades normales que se hayan producido desde el 1 de agosto.
Asimismo han pedido a los dueños de perros que limiten el contacto directo con otros canes.

“El Instituto Veterinario aún tiene que finalizar muchos análisis y la búsqueda de la causa de la enfermedad continuará probablemente durante un tiempo. Ahora pasaremos a hacer exámenes virológicos para buscar virus específicos”, consta en un comunicado.
Fue una clínica de Oslo la que dio el aviso la semana pasada a las autoridades, alertando de varios casos de perros muertos con síntomas similares en el área de la capital noruega.
Con información de EFE